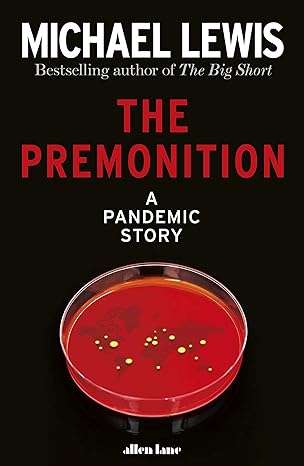
the premonition a pandemic story 1st edition michael lewis 0241512476, 978-0241512470

Statistics For Managers Using Microsoft Excel(4th Edition)
Authors:
David M. Levine, Mark L. Berenson, Patricia P. Ramsay, Davd M.Lvn
Type:Hardcover/ PaperBack / Loose Leaf
Condition: Used/New
In Stock: 2 Left
Shipment time
Expected shipping within 2 - 3 DaysPopular items with books
Access to 35 Million+ Textbooks solutions
Free ✝
Ask Unlimited Questions from expert
AI-Powered Answers
30 Min Free Tutoring Session
✝ 7 days-trial
Total Price:
$0
List Price: $25.00
Savings: $25
(100%)
Solution Manual Includes
Access to 30 Million+ solutions
Ask 50 Questions from expert
AI-Powered Answers
24/7 Tutor Help
Detailed solutions for Statistics For Managers Using Microsoft Excel
Price:
$9.99
/month
Book details
ISBN: 0131440543, 9780131440548
Book publisher: Prentice Hall
Offer Just for You!:
Buy 2 books before the end of January and enter our lucky draw.
Customers also bought these books
Popular Among Students
Customer Reviews
Trusted feedback from verified buyers
WF
This book provides a good balance of theory and practice, making it a valuable read for business managers looking to leverage statistics in real-world situations. The examples using Excel are particularly helpful. I took advantage of the membership benefits for a decent discount, which made the purchase more worthwhile. While the book is generally excellent, a few more diagrams could have been useful for visual learners. Nonetheless, the speed of delivery was impressive.
JF
This book is simply one of the best resources for managers who need to incorporate statistics into their work using Excel. It's comprehensive, detailed, and perfectly structured for both beginners and those needing a refresher. I got an extra discount with my membership, which was a nice bonus. The book arrived in perfect condition and earlier than expected. If you’re in management, this is a must-have.
SA
Statistics For Managers Using Microsoft Excel is absolutely outstanding. It breaks down complex statistical concepts into easy-to-understand chapters with plenty of practical examples. I've used it in my managerial role several times, and it hasn't let me down! The delivery was prompt and the book was well-packaged. Highly recommend this for anyone looking to delve deeper into the application of stats in management.
NW
Statistics For Managers Using Microsoft Excel has its strengths in providing a foundational understanding, but I felt it could've included more diverse case studies. It's decent for starting out, but advanced users might find it somewhat basic. It arrived quickly, though, and in good condition.